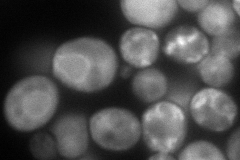
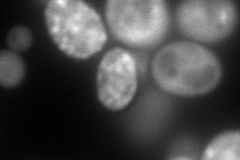
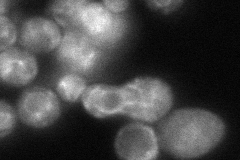

View description
Signal recognition particle (SRP) subunit (homolog of mammalian SRP54); contains the signal sequence-binding activity of SRP, interacts with the SRP RNA, and mediates binding of SRP to signal receptor; contains GTPase domain
Localization:
Intensity:
Fold change:
Significance:
-
C’ GFP library in SD

below threshold15.33 -
N' NOP1pr-GFP in SD
cytosol,ER,punctate188.593 -
N' TEF2pr-mCherry in SD
punctate152.542 -
N' NATIVEpr-GFP in SD
ER,punctate68.2451 -
N' TEF2pr-VC and Cyto-VN in SD

cytosol41.4464 -
C’ GFP library in SD+DTT

cytosol17.141.11No -
C’ GFP library in SD+H2O2

cytosol16.981.1No -
C’ GFP library in Starvation Media

cytosol14.030.91No -
C’ GFP library on the background of Pup2-DaMP

below threshold -
C’ GFP library on the background of CCT mutant

below threshold17.14811.11806No
